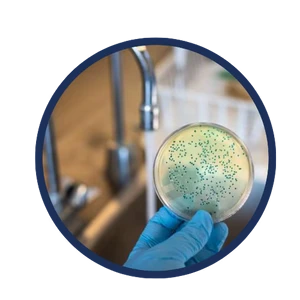
PLÍSNĚ

Odstraňuje více než 100 nečistot z vaší vody:
Snadná instalace bez odborníka
Není potřeba volat instalatéra — náš univerzální design pasuje na většinu kohoutků a instaluje se bez námahy. Postupujte podle přiloženého návodu a začněte si okamžitě užívat čistší a svěžejší vodu.

ÚČINNÝ PROTI VÍCE NEŽ 100 ŠKODLIVÝM LÁTKÁM
díky našim adaptérům, které jsou součástí každého balení
ročně na domácnost
vody z kohoutku a změkčuje ji
NEZÁVISLE TESTOVÁNO
Testováno a certifikováno nezávislými laboratořemi k potvrzení zdravotních přínosů a účinnosti.

PROČ POTŘEBUJETE PURESTREAM
POKROČILÁ TECHNOLOGIE
-
 NAŠE FILTRY
NAŠE FILTRYOdstranění více než 100 druhů nečistot
-
 INSTALACE
INSTALACEZáruka kompatibility s kohoutky
-
 VÍCE INFORMACÍ
VÍCE INFORMACÍ5 různých vestavěných filtračních vrstev
Názor našich zákazníků:
uvedlo, že jejich voda z kohoutku chutná svěžeji a čistěji po instalaci filtru Pure Stream.
by Pure Stream doporučilo svým přátelům a rodině.
snížilo svou spotřebu plastových lahví o více než polovinu.
*Na základě průzkumu mezi více než 200 současnými uživateli hodnotícími vnímanou účinnost.
Přihlaste se k odběru našeho newsletteru
Získejte exkluzivní slevy, novinky o produktech a tipy přímo do vaší e-mailové schránky.